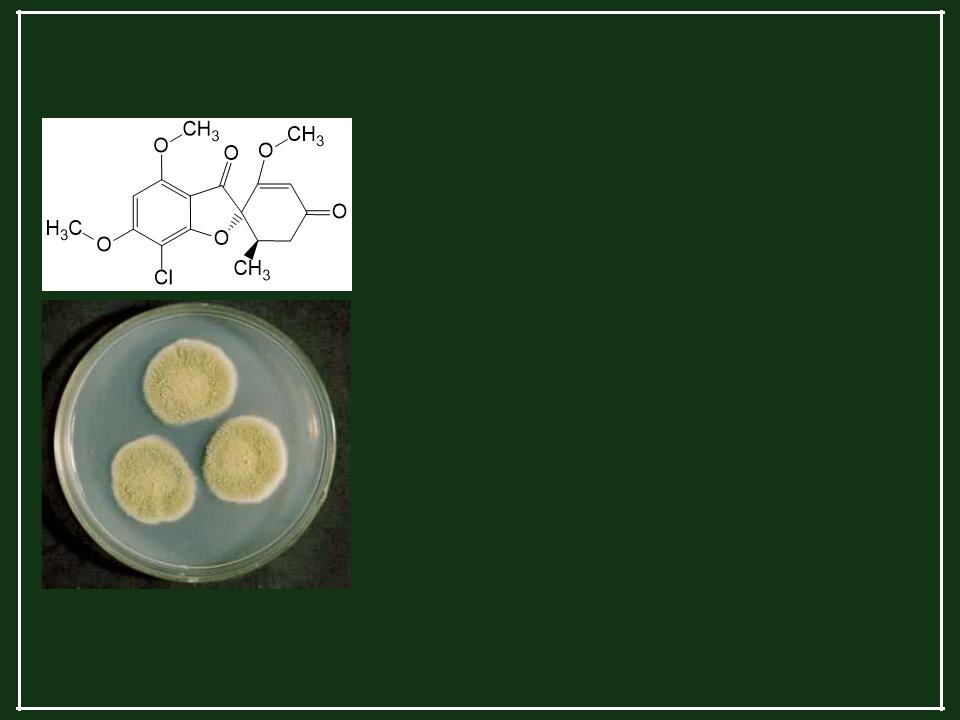

Материал: Лекарственные грибы

Грибные антибиотики в медицине: тритерпены
Фузидин (Na соль фузидиевой к-ты)
Сходен по строению со стероидными гормонами и холестерином.
Действие на грамположительные (Г+) бактерии, в том числе устойчивые к пенициллинам
(ингибирование синтеза белка).
Относительно нетоксичен, хотя известны аллергические реакции. Применяется в основном для лечения бронхитов и кожных заболеваний.
Продуцент - Acremonium fusidioides
Грибные антибиотики в медицине
Гризеофульвин
(1'S-транс)-7-Хлор-2',4,6-триметокси- 6'-метилспиро [бензофуран-2(3H),1'- [2]циклогексен]-3,4'-дион
Продуценты - Penicillium griseofulvum, P. nigricans, P. raistrickii и др.
Действие на мицелиальные грибы,
в т.ч. дерматофиты (нарушение митоза, синтеза белка и формирования клеточной стенки за счет влияния на цитоскелет).
Не обладает острой токсичностью, показано избирательное действие на деление опухолевых клеток.